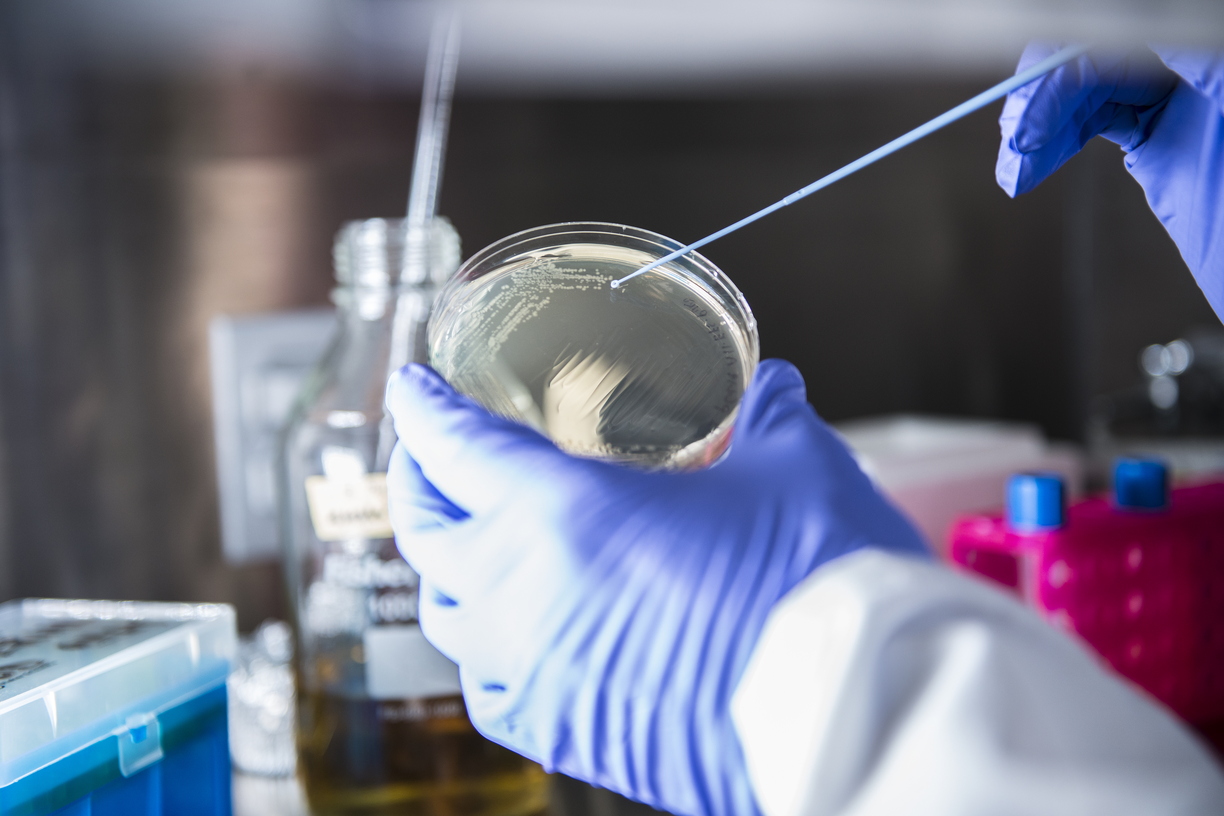

- Department of Biological Sciences
- Campus Experiences
- Facilities
- Research Instrumentation and Microscopy Core Laboratories
- Instrumentation
Instrumentation
Our laboratories house four HERAcell 150i incubators and three Thermo Napco 8000 WJ incubators, all with humidified atmospheric control, 5% CO2, flexible temperature settings and optional adaptation to a Pfeiffer Cellspin stirring platform for spinner flask cell culture; one Thermo Napco 8000 WJ incubator is connected to a nitrogen gas source for short-term hypoxic exposure; two laminar flow hoods (a.k.a. bio-safety cabinets): a Thermo Scientific 1300 Series Class II and a Baker Company SterilGARD VBM-600; a light microscope for standard bright-field visualization and equipped with a Nikon digital camera and NIS-Elements image capture and optimization software; and an EVOS FLoid cell imaging station for bright-field and red/green/blue fluorescence visualization and image capture.
EVOS Floid instrument specifications
Options for cell counting: a hemocytometer slide for manual counting; a Tali image-based cell counter and a Millipore Scepter handheld cell counter for automated counting. Single-use materials for Tali counting and for Scepter counting .
Our Neon® electroporation system is designed for eukaryotic cell transfections. Single-use materials for Neon transfection .


Samples can be homogenized with our Fisher Scientific cup horn sonication system and quantified with our Thermo Scientific NanoDrop 2000 spectrophotometer and NanoDrop 2000/2000c quantification and spectral analysis software. Western blot analysis is performed using a Bio-Rad Mini-PROTEAN Tetra vertical electrophoresis and Western blotting system, and single-use precast gels compatible with the Mini-PROTEAN system .

RNA sample preparation and analysis: clean sample preparation can be performed in our Fisher Scientific PCR workstation, and standard PCR reactions can be run on our Applied Biosystems SimpliAmp thermocycler and then visualized on our Invitrogen Life Technologies E-Gel Imager with GelQuant Express analysis software and GelCapture acquisition software. For RT-qPCR applications, we have an Eppendorf Mastercycler Realplex and single-use 96-well plates compatible with this Eppendorf RT-qPCR instrument .
- Epoch UV-Vis microplate spectrophotometer - specifications .
- Cytation 5 microplate spectrophotometer with UV-Vis absorbance, fluorescence and luminescence detection spectrophotometer - specifications (please note: this instrument does not have the imaging module).
- Centro XS³ LB 960 luminometer.
To facilitate bacterial cell culture our microbiology laboratory is equipped with a Baker Company SterilGARD VBM-600 laminar flow hood (a.k.a. bio-safety cabinet), a large floor model Lab-Line orbital incubator shaker, three general purpose benchtop incubators, a New Brunswick C24 benchtop incubator shaker, an Eppendorf biophotometer with quartz crystal cuvettes, a Lab-Line Shak-R-Bath, a Cole-Parmer UV crosslinker, a large refrigerated benchtop centrifuges, a small room temperature microfuge, a water bath, gas line and Bunsen burner adaptors, a chemical fume hood, gram scales and differential storages (4°C and -20°C).
- Room 119
- Chemical fume hood
- Large and small benchtop centrifuges
- Mettler Toledo S20 SevenEasy pH meter
- Fisher Scientific Isotemp block heater
- Dry metal bead bath
- Microplate shaker
- Vortexes
- Gram and milligram scales
- Barnstead Nanopure Ultrapure water system
- Differential storages (4°C, -20°C, -80°C, and -190°C liquid nitrogen cryopreserve)
- Room 113
- Chemical fume hood
- Thermo Scientific Savant SpeedVac vacuum concentrator
- Wescor Vapro vapor pressure osmometer
- Gram and milligram scales
- Barnstead Nanopure Ultrapure water system
- Differential storages (37°C, 4°C, and -20°C)
Contact Us
Barrie Bode, Ph.D.
Core Lab Director
COVID-19 Waste Water Surveillance
Professor, Biological Sciences
bodebp@niu.edu








